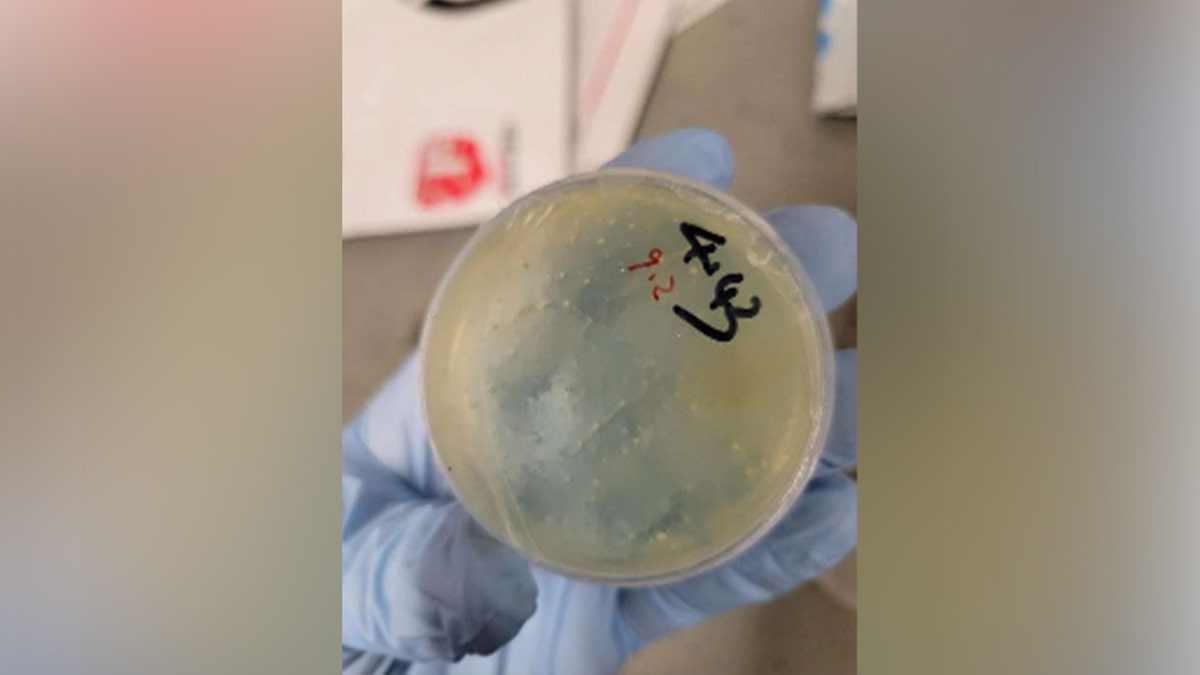
Chengxuan Han is facing multiple federal charges after allegedly mailing numerous biological samples from China to the United States.

NEWYou can now listen to Fox News articles!
Three Chinese nationals have been charged with conspiring to smuggle biological materials into the U.S. while they were employees at a University of Michigan laboratory.
Xu Bai, 28, Fengfan Zhang, 27, and Zhiyong Zhang, 30, were charged on Wednesday after allegedly making false statements to U.S. Customs and Border Protection (CBP) in order to import materials that were related to roundworms sent from China under the cover of research at the University of Michigan, according to prosecutors.
The Chinese nationals worked at the University of Michigan’s Shawn Xu laboratory. Chengxuan Han, who also previously worked at the laboratory, was earlier charged with smuggling and making false statements. She pleaded no contest before being removed from the U.S.
After Han’s removal from the U.S., the university launched an internal investigation. Bai, Zhang and Zhang refused to cooperate with the investigation and were terminated, which made them eligible for deportation. The three allegedly tried to board a flight to China on Oct. 16 from John F. Kennedy International Airport when they were stopped for further inspection.
CHINESE DOCTOR ACCUSED OF ATTEMPTING TO SMUGGLE CANCER RESEARCH FROM US TO CHINA
Here’s what we know about the three Chinese nationals charged:
Xu Bai
Bai was in the U.S. under the J-1 visa academic exchange program at the University of Michigan and charged with conspiring to smuggle biological materials into the United States.
Han, a researcher at Huazhong University of Science and Technology, allegedly sent Bai a shipment that was intercepted by CBP. While the package was described as “doc” in the manifest, a further inspection allegedly found a book with an “envelope tucked into the middle of the pages.”
CHINESE SCHOLARS CHARGED WITH SMUGGLING BIOLOGICAL MATERIALS INTO US UNDER RESEARCH COVER

According to court documents, the envelope allegedly contained a “handwritten note with 28 shapes and a labeling scheme with each shape.” Prosecutors allege that the labels instead contained “biological materials related to round worms.”
Bai allegedly refused to cooperate with CBP officials as well as an internal investigation by the University of Michigan. When Bai was interviewed by CBP at John F. Kennedy International Airport, he allegedly said that Han is a Chinese Communist Party member and a leader of the biology department at Huazhong University of Science and Technology.
Bai was terminated by the University of Michigan in October after he refused to participate in an internal investigation under advice of his lawyer, according to court documents, adding he was trying to fly back to China to continue studying at Huazhong University of Science and Technology.
Court documents indicate he shared an apartment with Zhang.
US UNIVERSITIES TRAINING CHINESE MILITARY SCIENTISTS ON TAXPAYER DIME, COMMITTEE WARNS

Fengfan Zhang
Zhang was also in the U.S. under the J-1 visa academic exchange program at the University of Michigan and charged with conspiring to smuggle biological materials into the United States.
Han allegedly sent five packages to Zhang under the name “Dylan Zhang” which contained the following biological materials:
– “PRK 5” plasmids
– “C. elegans with genetic modifications”
– “HA Cluk1 Rat” plasmids
Prosecutors allege that all of the shipments were improperly manifested as “glass sheet” and “doc.”
During an interview with CBP in October, Zhang became “nervous” when asked if he received packages from Han. He was terminated from the University of Michigan in October and lost his visa status. He was arrested at John F. Kennedy International Airport on Oct. 16 with the other co-defendants.
CHINESE NATIONAL WHO OVERSTAYED VISA LEARNS FATE FOR EXPORTING WEAPONS TO NORTH KOREA
Zhiyong Zhang
Zhang was in the U.S. under the J-1 visa academic exchange program at the University of Michigan and charged with conspiring to smuggle biological materials into the United States.
Between 2019 and 2023, Zhang allegedly sent several packages from Huazhong University of Science and Technology that were manifested as “plastic plates.” When one of the packages was intercepted by CBP, they allegedly found they contained “petri dishes containing nematodes.”
He was arrested at John F. Kennedy International Airport on Oct. 16 with the other co-defendants.
CLICK HERE TO DOWNLOAD THE FOX NEWS APP
ICE Director Todd M. Lyons said in a statement that the incident shows the need for universities to change their admissions procedures.
“This case underscores the vital importance of safeguarding the American people and addressing vulnerabilities within foreign student and exchange visitor programs,” Lyons said. “Educational institutions must enhance their admissions procedures to prevent exploitation, which can pose risks to national security.”
U.S. Attorney Jerome Gorgon said the alleged criminal activity by the researchers is part of a pattern.
“These three men are part of a long and alarming pattern of criminal activities committed by Chinese nationals under the cover of the University of Michigan,” Gorgen said.
Fox News Digital’s Bonny Chu contributed to this report.
Read the full article here

